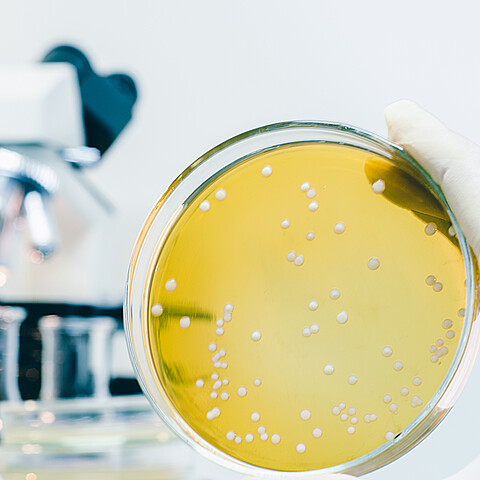
Bacteria

Katarina Hall

Katarina is a news reporter at ADN America, with a background as a former Innovation Fellow who conducted research on tech policy, transportation, cities, cryptocurrencies, and immigration. She holds a master's degree in political economy from NYU, with field research experience in Latin America on remittances, the tech sector, informal parking markets, and local insecurity. Katarina's work has been featured in Forbes, CNN Espanol, Washington Examiner, and Real Clear World, among others. She was a Frédéric Bastiat fellow at the Mercatus Center and earned her BA in economic and social history at Universidad Francisco Marroquin in Guatemala.